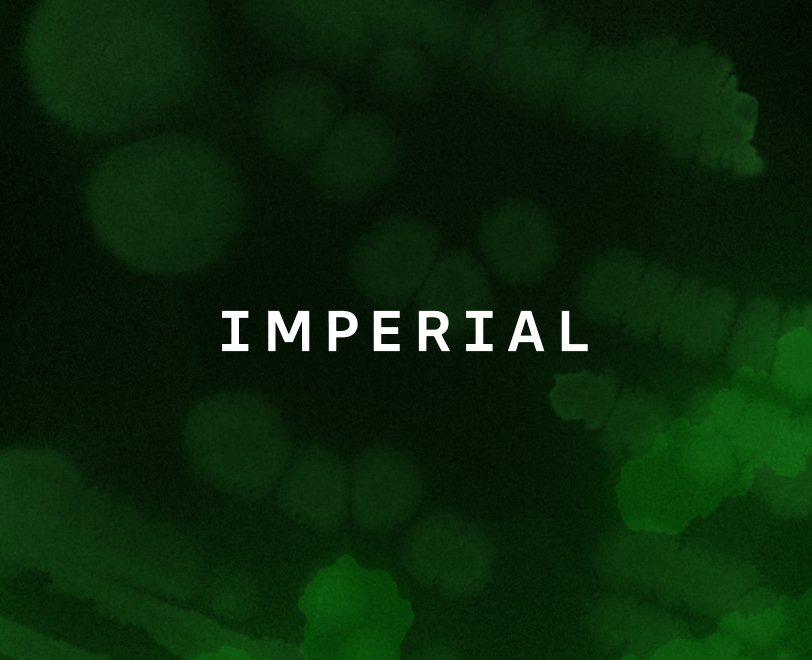
Imperial

How Food Brewer boosts media screening accuracy using Reshape’s imaging technology
Food Brewer, a pioneer in plant cellular agriculture, improved growth tracking and reduced experiment cycles with Reshape’s imaging device, gaining more accurate, reliable image input to scale sustainable cacao and coffee production.
Fewer false positives
Standardized imaging cut errors in growth predictions
+50% faster experimentation
Going from manual to automated media screening
Quantitative growth measurement
Transillumination imaging enabled mass‑prediction algorithms




“Our work revolves around designing high-throughput workflows to scale plant cell cultures, and for that, reliable, high-quality image data is essential.”

Christopher Keim,
Head of Process Automation